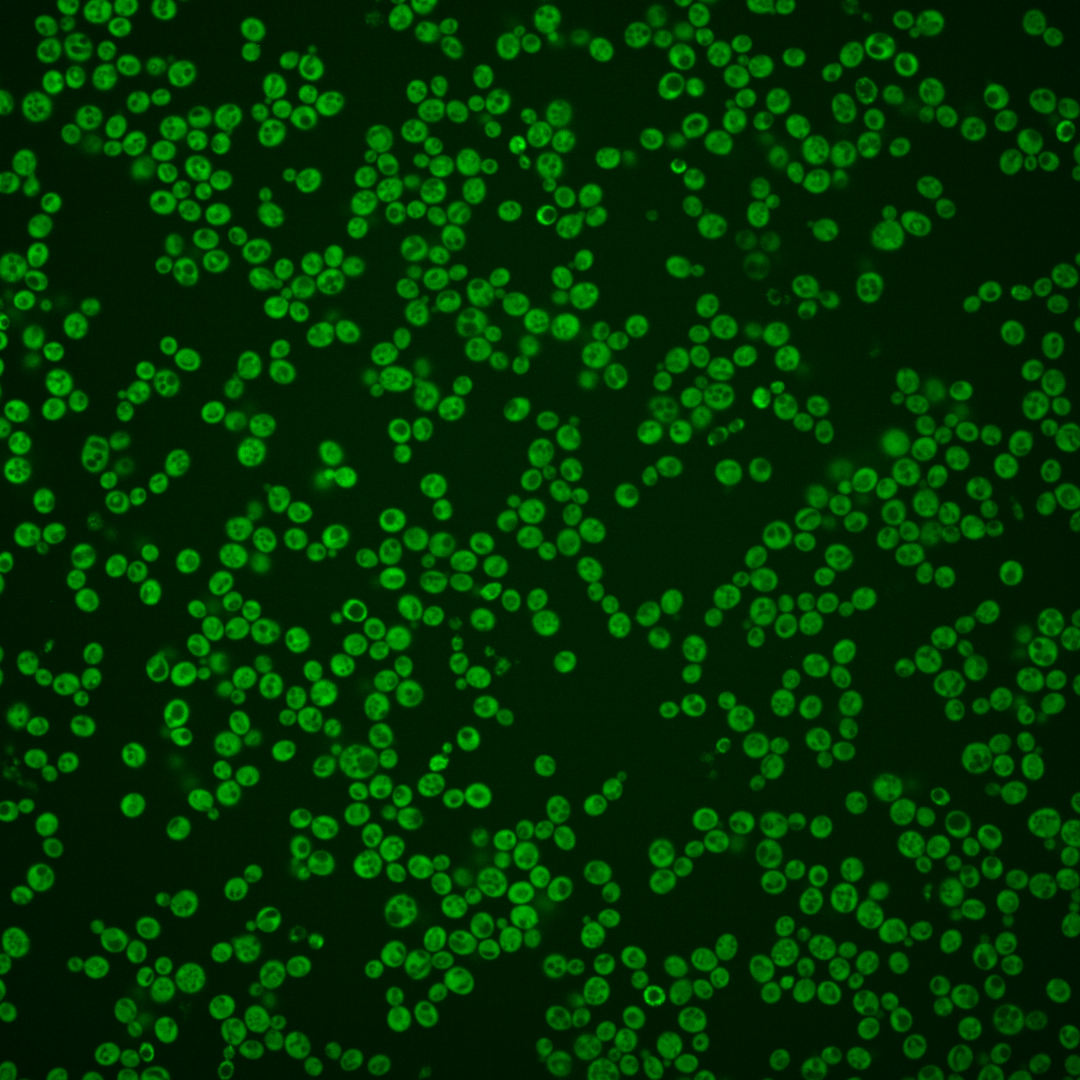
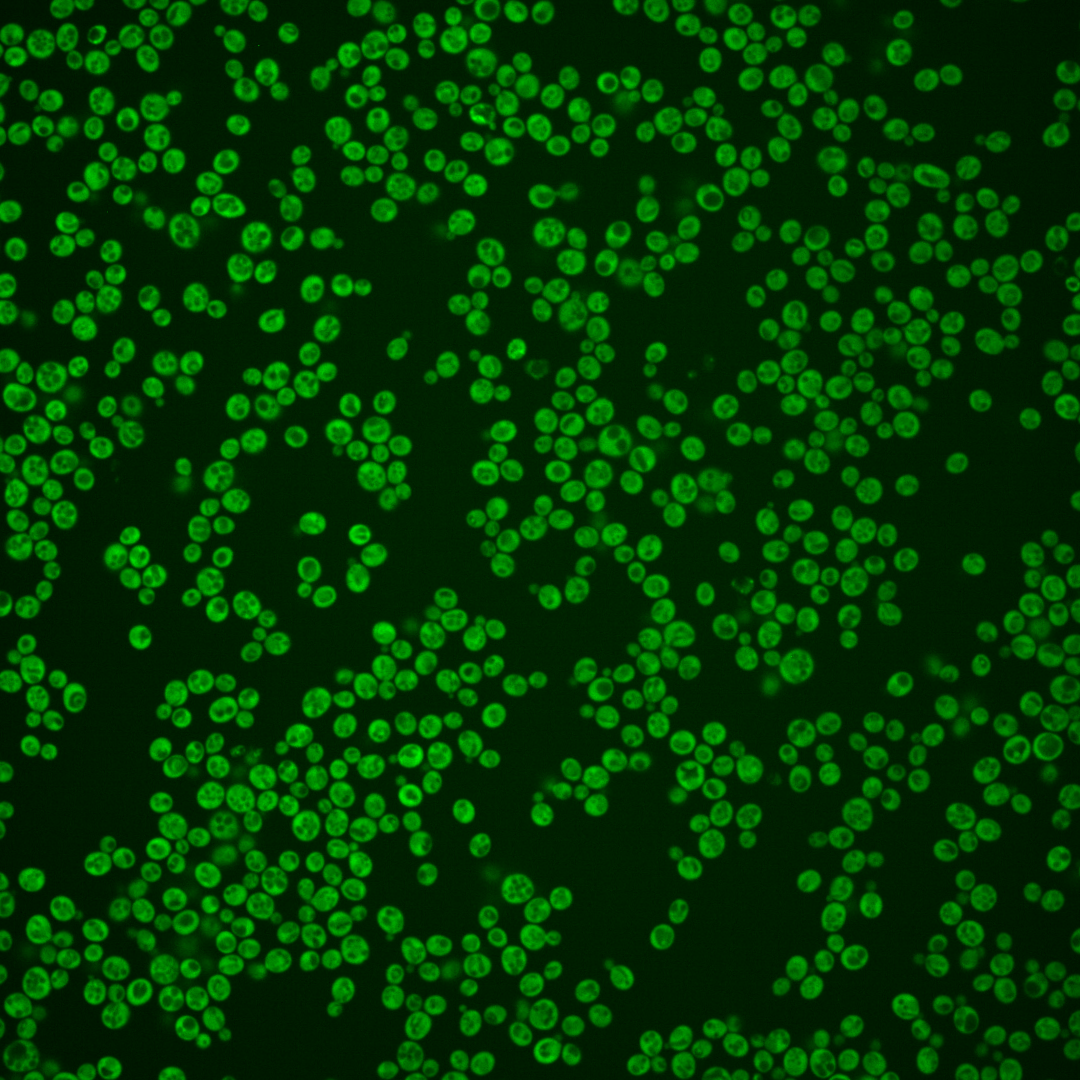

| Standard name | |
|---|---|
| Human Ortholog | |
| Description | AMP deaminase; tetrameric enzyme that catalyzes the deamination of AMP to form IMP and ammonia; thought to be involved in regulation of intracellular purine (adenine, guanine, and inosine) nucleotide pools |
Micrographs




















































































Sub-cellular Localization
Yeast GFP Assignment
Protein Abundance
Localization Change
External localization resources
| ensLOC | DeepLoc | |||||||||||||||||||||||
|---|---|---|---|---|---|---|---|---|---|---|---|---|---|---|---|---|---|---|---|---|---|---|---|---|
| Localization | WT1 | WT2 | WT3 | RAP60 | RAP140 | RAP220 | RAP300 | RAP380 | RAP460 | RAP540 | RAP620 | RAP700 | HU80 | HU120 | HU160 | rpd3Δ_1 | rpd3Δ_2 | rpd3Δ_3 | WT1 | WT2 | WT3 | AF100 | AF140 | AF180 |
| Cortical Patches | 1 | 0 | 0 | 0 | 0 | 0 | 4 | 6 | 4 | 4 | 7 | 3 | 0 | 0 | 1 | 0 | 1 | 0 | 0 | 0 | 0 | 0 | 0 | 0 |
| Bud | 0 | 1 | 0 | 0 | 0 | 0 | 1 | 0 | 1 | 1 | 4 | 3 | 3 | 0 | 0 | 0 | 0 | 0 | 0 | 0 | 0 | 0 | 2 | 0 |
| Bud Neck | 0 | 0 | 0 | 0 | 0 | 0 | 0 | 0 | 0 | 0 | 0 | 0 | 0 | 0 | 0 | 0 | 0 | 0 | 0 | 0 | 0 | 0 | 0 | 1 |
| Bud Site | 0 | 0 | 0 | 0 | 0 | 0 | 0 | 0 | 0 | 0 | 0 | 0 | 0 | 0 | 0 | 0 | 0 | 0 | – | – | – | – | – | – |
| Cell Periphery | 2 | 2 | 3 | 4 | 10 | 0 | 4 | 5 | 6 | 5 | 7 | 7 | 4 | 7 | 6 | 6 | 4 | 3 | 0 | 0 | 0 | 2 | 0 | 0 |
| Cytoplasm | 256 | 211 | 172 | 166 | 211 | 98 | 176 | 153 | 123 | 116 | 149 | 123 | 250 | 352 | 387 | 78 | 74 | 82 | 256 | 207 | 171 | 184 | 250 | 251 |
| Endoplasmic Reticulum | 7 | 3 | 2 | 2 | 5 | 1 | 10 | 10 | 3 | 4 | 17 | 15 | 2 | 5 | 6 | 3 | 7 | 2 | 4 | 1 | 4 | 23 | 41 | 21 |
| Endosome | 0 | 0 | 0 | 0 | 0 | 0 | 0 | 0 | 0 | 1 | 0 | 0 | 0 | 0 | 0 | 0 | 0 | 0 | 1 | 1 | 0 | 0 | 0 | 0 |
| Golgi | 0 | 0 | 0 | 0 | 1 | 0 | 0 | 0 | 0 | 0 | 0 | 2 | 0 | 1 | 0 | 1 | 0 | 0 | 3 | 0 | 0 | 0 | 1 | 0 |
| Mitochondria | 1 | 1 | 0 | 0 | 4 | 15 | 27 | 24 | 43 | 61 | 78 | 73 | 2 | 0 | 1 | 0 | 2 | 1 | 0 | 3 | 5 | 2 | 4 | 2 |
| Nucleus | 2 | 0 | 0 | 2 | 2 | 2 | 3 | 2 | 2 | 8 | 3 | 6 | 1 | 1 | 2 | 1 | 0 | 0 | 0 | 0 | 0 | 0 | 0 | 0 |
| Nuclear Periphery | 0 | 0 | 0 | 0 | 0 | 0 | 0 | 0 | 0 | 0 | 0 | 0 | 0 | 0 | 0 | 0 | 0 | 0 | 0 | 0 | 0 | 0 | 0 | 0 |
| Nucleolus | 0 | 0 | 0 | 1 | 0 | 0 | 0 | 0 | 0 | 0 | 0 | 1 | 0 | 0 | 0 | 0 | 0 | 0 | 0 | 0 | 0 | 0 | 0 | 0 |
| Peroxisomes | 0 | 0 | 0 | 0 | 0 | 0 | 0 | 0 | 0 | 0 | 0 | 0 | 0 | 0 | 0 | 0 | 0 | 0 | 0 | 0 | 0 | 0 | 0 | 0 |
| SpindlePole | 0 | 0 | 0 | 0 | 0 | 0 | 0 | 0 | 0 | 0 | 0 | 0 | 0 | 0 | 0 | 0 | 0 | 0 | 0 | 0 | 0 | 0 | 1 | 0 |
| Vac/Vac Membrane | 0 | 0 | 0 | 1 | 4 | 2 | 7 | 12 | 8 | 20 | 18 | 12 | 1 | 1 | 2 | 1 | 0 | 1 | 1 | 12 | 2 | 8 | 12 | 16 |
| Unique Cell Count | 264 | 216 | 174 | 169 | 227 | 107 | 215 | 190 | 162 | 180 | 233 | 204 | 255 | 359 | 395 | 81 | 78 | 83 | 271 | 228 | 189 | 226 | 320 | 300 |
| Labelled Cell Count | 269 | 218 | 177 | 176 | 237 | 118 | 232 | 212 | 190 | 220 | 283 | 245 | 263 | 367 | 405 | 90 | 88 | 89 | 271 | 228 | 189 | 226 | 320 | 300 |
Yeast GFP Assignment
Protein Abundance
| Screen | WT1 | WT2 | WT3 | RAP60 | RAP140 | RAP220 | RAP300 | RAP380 | RAP460 | RAP540 | RAP620 | RAP700 | HU80 | HU120 | HU160 | rpd3Δ_1 | rpd3Δ_2 | rpd3Δ_3 | AF100 | AF140 | AF180 |
|---|---|---|---|---|---|---|---|---|---|---|---|---|---|---|---|---|---|---|---|---|---|
| Mean Cell GFP Intensity (1e-4) | 11.5 | 10.2 | 10.0 | 9.2 | 9.6 | 7.6 | 8.6 | 8.7 | 7.8 | 7.4 | 7.5 | 7.6 | 11.6 | 12.4 | 12.4 | 18.0 | 18.6 | 17.6 | 10.5 | 10.5 | 11.3 |
| Std Deviation (1e-4) | 1.7 | 2.0 | 1.6 | 1.5 | 1.3 | 1.5 | 1.6 | 1.5 | 1.7 | 1.7 | 1.6 | 1.4 | 1.9 | 2.0 | 2.1 | 3.6 | 4.0 | 2.6 | 1.5 | 2.0 | 2.0 |
| Intensity Change (Log2) | – | – | – | -0.12 | -0.05 | -0.39 | -0.22 | -0.2 | -0.35 | -0.44 | -0.42 | -0.39 | 0.22 | 0.31 | 0.31 | 0.85 | 0.9 | 0.82 | 0.07 | 0.07 | 0.18 |
Localization Change
| Localization | RAP60 | RAP140 | RAP220 | RAP300 | RAP380 | RAP460 | RAP540 | RAP620 | RAP700 | HU80 | HU120 | HU160 | rpd3Δ_1 | rpd3Δ_2 | rpd3Δ_3 |
|---|---|---|---|---|---|---|---|---|---|---|---|---|---|---|---|
| Cortical Patches | 0 | 0 | 0 | 0 | 0 | 0 | 0 | 0 | 0 | 0 | 0 | 0 | 0 | 0 | 0 |
| Bud | 0 | 0 | 0 | 0 | 0 | 0 | 0 | 0 | 0 | 0 | 0 | 0 | 0 | 0 | 0 |
| Bud Neck | 0 | 0 | 0 | 0 | 0 | 0 | 0 | 0 | 0 | 0 | 0 | 0 | 0 | 0 | 0 |
| Bud Site | 0 | 0 | 0 | 0 | 0 | 0 | 0 | 0 | 0 | 0 | 0 | 0 | 0 | 0 | 0 |
| Cell Periphery | 0 | 1.5 | 0 | 0 | 0 | 0 | 0 | 0 | 0 | 0 | 0 | 0 | 0 | 0 | 0 |
| Cytoplasm | -0.5 | -2.8 | -3.0 | -5.4 | -5.6 | -6.4 | -8.3 | -8.5 | -9.0 | -0.7 | -0.7 | -0.7 | -1.4 | -1.9 | 0 |
| Endoplasmic Reticulum | 0 | 0 | 0 | 2.0 | 2.2 | 0 | 0 | 2.9 | 2.9 | 0 | 0 | 0 | 0 | 0 | 0 |
| Endosome | 0 | 0 | 0 | 0 | 0 | 0 | 0 | 0 | 0 | 0 | 0 | 0 | 0 | 0 | 0 |
| Golgi | 0 | 0 | 0 | 0 | 0 | 0 | 0 | 0 | 0 | 0 | 0 | 0 | 0 | 0 | 0 |
| Mitochondria | 0 | 0 | 5.1 | 4.8 | 4.9 | 7.3 | 8.4 | 8.5 | 8.8 | 0 | 0 | 0 | 0 | 0 | 0 |
| Nucleus | 0 | 0 | 0 | 0 | 0 | 0 | 0 | 0 | 0 | 0 | 0 | 0 | 0 | 0 | 0 |
| Nuclear Periphery | 0 | 0 | 0 | 0 | 0 | 0 | 0 | 0 | 0 | 0 | 0 | 0 | 0 | 0 | 0 |
| Nucleolus | 0 | 0 | 0 | 0 | 0 | 0 | 0 | 0 | 0 | 0 | 0 | 0 | 0 | 0 | 0 |
| Peroxisomes | 0 | 0 | 0 | 0 | 0 | 0 | 0 | 0 | 0 | 0 | 0 | 0 | 0 | 0 | 0 |
| SpindlePole | 0 | 0 | 0 | 0 | 0 | 0 | 0 | 0 | 0 | 0 | 0 | 0 | 0 | 0 | 0 |
| Vacuole | 0 | 0 | 0 | 0 | 3.4 | 0 | 4.5 | 3.8 | 3.3 | 0 | 0 | 0 | 0 | 0 | 0 |
External localization resources
Images






























Protein Concentration and Protein Localization Data
| R1 | R2 | R3 | ||||||||||||||||
|---|---|---|---|---|---|---|---|---|---|---|---|---|---|---|---|---|---|---|
| G1 Pre-START | G1 Post-START | S/G2 | Metaphase | Anaphase | Telophase | G1 Pre-START | G1 Post-START | S/G2 | Metaphase | Anaphase | Telophase | G1 Pre-START | G1 Post-START | S/G2 | Metaphase | Anaphase | Telophase | |
| Concentration | 7.9458 | 11.2518 | 10.0882 | 9.198 | 7.9276 | 10.3809 | 6.7206 | 9.743 | 8.5441 | 8.5456 | 6.8227 | 8.5603 | 5.5303 | 8.4477 | 7.3848 | 7.0209 | 6.8453 | 7.36 |
| Actin | 0.0305 | 0.0007 | 0.0238 | 0.0001 | 0.1348 | 0.0006 | 0.063 | 0.0005 | 0.018 | 0.0471 | 0.0621 | 0.0058 | 0.0475 | 0.0014 | 0.0446 | 0.0003 | 0.0081 | 0.0004 |
| Bud | 0.0006 | 0.0005 | 0.0007 | 0.0008 | 0.0008 | 0.0005 | 0.0015 | 0.0004 | 0.0017 | 0.0007 | 0.0023 | 0.0003 | 0.0015 | 0.0003 | 0.001 | 0.0005 | 0.0005 | 0.0003 |
| Bud Neck | 0.0011 | 0.0006 | 0.0006 | 0.0006 | 0.0036 | 0.0012 | 0.0013 | 0.0002 | 0.0008 | 0.0018 | 0.0011 | 0.001 | 0.0015 | 0.0003 | 0.0005 | 0.0003 | 0.0005 | 0.0008 |
| Bud Periphery | 0.0012 | 0.0002 | 0.0005 | 0.0003 | 0.0008 | 0.0009 | 0.0014 | 0.0001 | 0.0011 | 0.0004 | 0.0037 | 0.0003 | 0.0011 | 0.0001 | 0.0007 | 0.0001 | 0.0003 | 0.0002 |
| Bud Site | 0.0021 | 0.0023 | 0.0019 | 0.0008 | 0.0021 | 0.0003 | 0.0067 | 0.0009 | 0.0062 | 0.0022 | 0.0055 | 0.0001 | 0.0121 | 0.0008 | 0.0011 | 0.0002 | 0.0005 | 0.0001 |
| Cell Periphery | 0.0016 | 0.0007 | 0.0006 | 0.0017 | 0.0004 | 0.0005 | 0.0005 | 0.0002 | 0.0003 | 0.0001 | 0.0006 | 0.0002 | 0.0005 | 0.0003 | 0.0002 | 0.0002 | 0.0001 | 0.0001 |
| Cytoplasm | 0.7031 | 0.937 | 0.8601 | 0.8509 | 0.6478 | 0.8335 | 0.752 | 0.9596 | 0.8553 | 0.7296 | 0.6335 | 0.8921 | 0.7411 | 0.9493 | 0.8418 | 0.9102 | 0.8535 | 0.8789 |
| Cytoplasmic Foci | 0.0282 | 0.0073 | 0.0128 | 0.0159 | 0.0322 | 0.0148 | 0.0257 | 0.0086 | 0.0207 | 0.048 | 0.0383 | 0.0137 | 0.033 | 0.011 | 0.0123 | 0.0145 | 0.023 | 0.0141 |
| Eisosomes | 0.0009 | 0 | 0.0001 | 0 | 0.001 | 0 | 0.0003 | 0 | 0.0001 | 0.0002 | 0.0005 | 0.0001 | 0.0005 | 0 | 0.0002 | 0 | 0.0001 | 0 |
| Endoplasmic Reticulum | 0.0728 | 0.0254 | 0.0139 | 0.0031 | 0.0269 | 0.0655 | 0.0217 | 0.0029 | 0.0096 | 0.0144 | 0.0085 | 0.0274 | 0.0314 | 0.0046 | 0.0158 | 0.0121 | 0.0027 | 0.0271 |
| Endosome | 0.0571 | 0.0122 | 0.0351 | 0.0706 | 0.0459 | 0.0497 | 0.0726 | 0.0122 | 0.045 | 0.0944 | 0.1068 | 0.0342 | 0.0767 | 0.0162 | 0.0443 | 0.0447 | 0.0419 | 0.0473 |
| Golgi | 0.0108 | 0.0024 | 0.0052 | 0.0032 | 0.0122 | 0.0059 | 0.015 | 0.0024 | 0.0134 | 0.0133 | 0.0439 | 0.0107 | 0.014 | 0.0092 | 0.0082 | 0.0022 | 0.0237 | 0.0054 |
| Lipid Particles | 0.0124 | 0.0001 | 0.0018 | 0.0002 | 0.0153 | 0.0002 | 0.0034 | 0.0001 | 0.0032 | 0.0029 | 0.0042 | 0.0002 | 0.0039 | 0.0001 | 0.0029 | 0.0001 | 0.0003 | 0.0001 |
| Mitochondria | 0.006 | 0.0008 | 0.0128 | 0.0008 | 0.0036 | 0.008 | 0.0058 | 0.0009 | 0.0066 | 0.0039 | 0.0324 | 0.0076 | 0.0068 | 0.0018 | 0.0036 | 0.0006 | 0.0379 | 0.0188 |
| None | 0.0239 | 0.0013 | 0.0058 | 0.0007 | 0.0086 | 0.0009 | 0.0025 | 0.0014 | 0.0009 | 0.0008 | 0.0014 | 0.0006 | 0.0035 | 0.0007 | 0.0017 | 0.0008 | 0.0012 | 0.0006 |
| Nuclear Periphery | 0.0074 | 0.001 | 0.0064 | 0.0012 | 0.0023 | 0.0017 | 0.0089 | 0.0004 | 0.0015 | 0.0009 | 0.0062 | 0.0008 | 0.0026 | 0.0004 | 0.0038 | 0.001 | 0.0004 | 0.0008 |
| Nucleolus | 0.0024 | 0 | 0.0001 | 0 | 0.0022 | 0 | 0.0001 | 0 | 0.0001 | 0 | 0.0004 | 0 | 0.0003 | 0 | 0.0001 | 0 | 0 | 0 |
| Nucleus | 0.0028 | 0.0008 | 0.0021 | 0.0017 | 0.0016 | 0.001 | 0.0035 | 0.0006 | 0.0009 | 0.0007 | 0.0022 | 0.0005 | 0.0014 | 0.0005 | 0.001 | 0.0009 | 0.0005 | 0.0006 |
| Peroxisomes | 0.0154 | 0 | 0.0028 | 0.0001 | 0.0272 | 0.0001 | 0.002 | 0.0001 | 0.0025 | 0.0141 | 0.0043 | 0.0001 | 0.0031 | 0.0002 | 0.0023 | 0 | 0.0008 | 0.0001 |
| Punctate Nuclear | 0.0042 | 0.0001 | 0.0013 | 0.0001 | 0.0172 | 0.0001 | 0.0013 | 0.0001 | 0.0009 | 0.0006 | 0.0243 | 0 | 0.0013 | 0 | 0.0018 | 0.0001 | 0.0001 | 0 |
| Vacuole | 0.0128 | 0.0056 | 0.0093 | 0.0411 | 0.0106 | 0.0103 | 0.0087 | 0.0079 | 0.0092 | 0.0166 | 0.0126 | 0.0029 | 0.0135 | 0.0023 | 0.0097 | 0.0087 | 0.0029 | 0.0027 |
| Vacuole Periphery | 0.0027 | 0.0008 | 0.0023 | 0.0062 | 0.003 | 0.0044 | 0.0019 | 0.0007 | 0.0021 | 0.0072 | 0.0055 | 0.0015 | 0.0029 | 0.0004 | 0.0025 | 0.0024 | 0.0012 | 0.0016 |
Sequencing Data
| R1 | R2 | |||||||||
|---|---|---|---|---|---|---|---|---|---|---|
| G1 Post-START | S/G2 | Metaphase | Anaphase | Telophase | G1 Post-START | S/G2 | Metaphase | Anaphase | Telophase | |
| Gene Expression | 56.6895 | 42.5686 | 49.6379 | 58.5293 | 42.3362 | 52.5787 | 51.8543 | 56.8547 | 59.8608 | 54.6118 |
| Translational Efficiency | 1.1438 | 1.2269 | 1.2457 | 1.0337 | 1.1647 | 1.3749 | 1.0673 | 1.0001 | 1.0641 | 0.9653 |
Hit Data
| Dataset | Hit |
|---|---|
| Protein Concentration | ✘ |
| Protein Localization | ✘ |
| Gene Expression | ✘ |
| Translational Efficiency | ✘ |
Endocytosis
| Temp | Actin Patch (Sac6-tdTomato) | Cortical Patch (Sla1-GFP) | Late Endosome (Snf7-GFP) | Vacuole (Vph1-GFP) |
|---|---|---|---|---|
| 37℃ | ||||
| RT |
Cell Cycle Omics
CYCLoPs (Amd1-GFP)
| Gene / Allele | Actin Patch (Sac6-tdTomato) | Cortical Patch (Sla1-GFP) | Late Endosome (Snf7-GFP) | Vacuole (Sac6-tdTomato) |
|---|
| Gene | Images |
|---|
| Gene | Images |
|---|
Images are not yet available
Images are not yet available